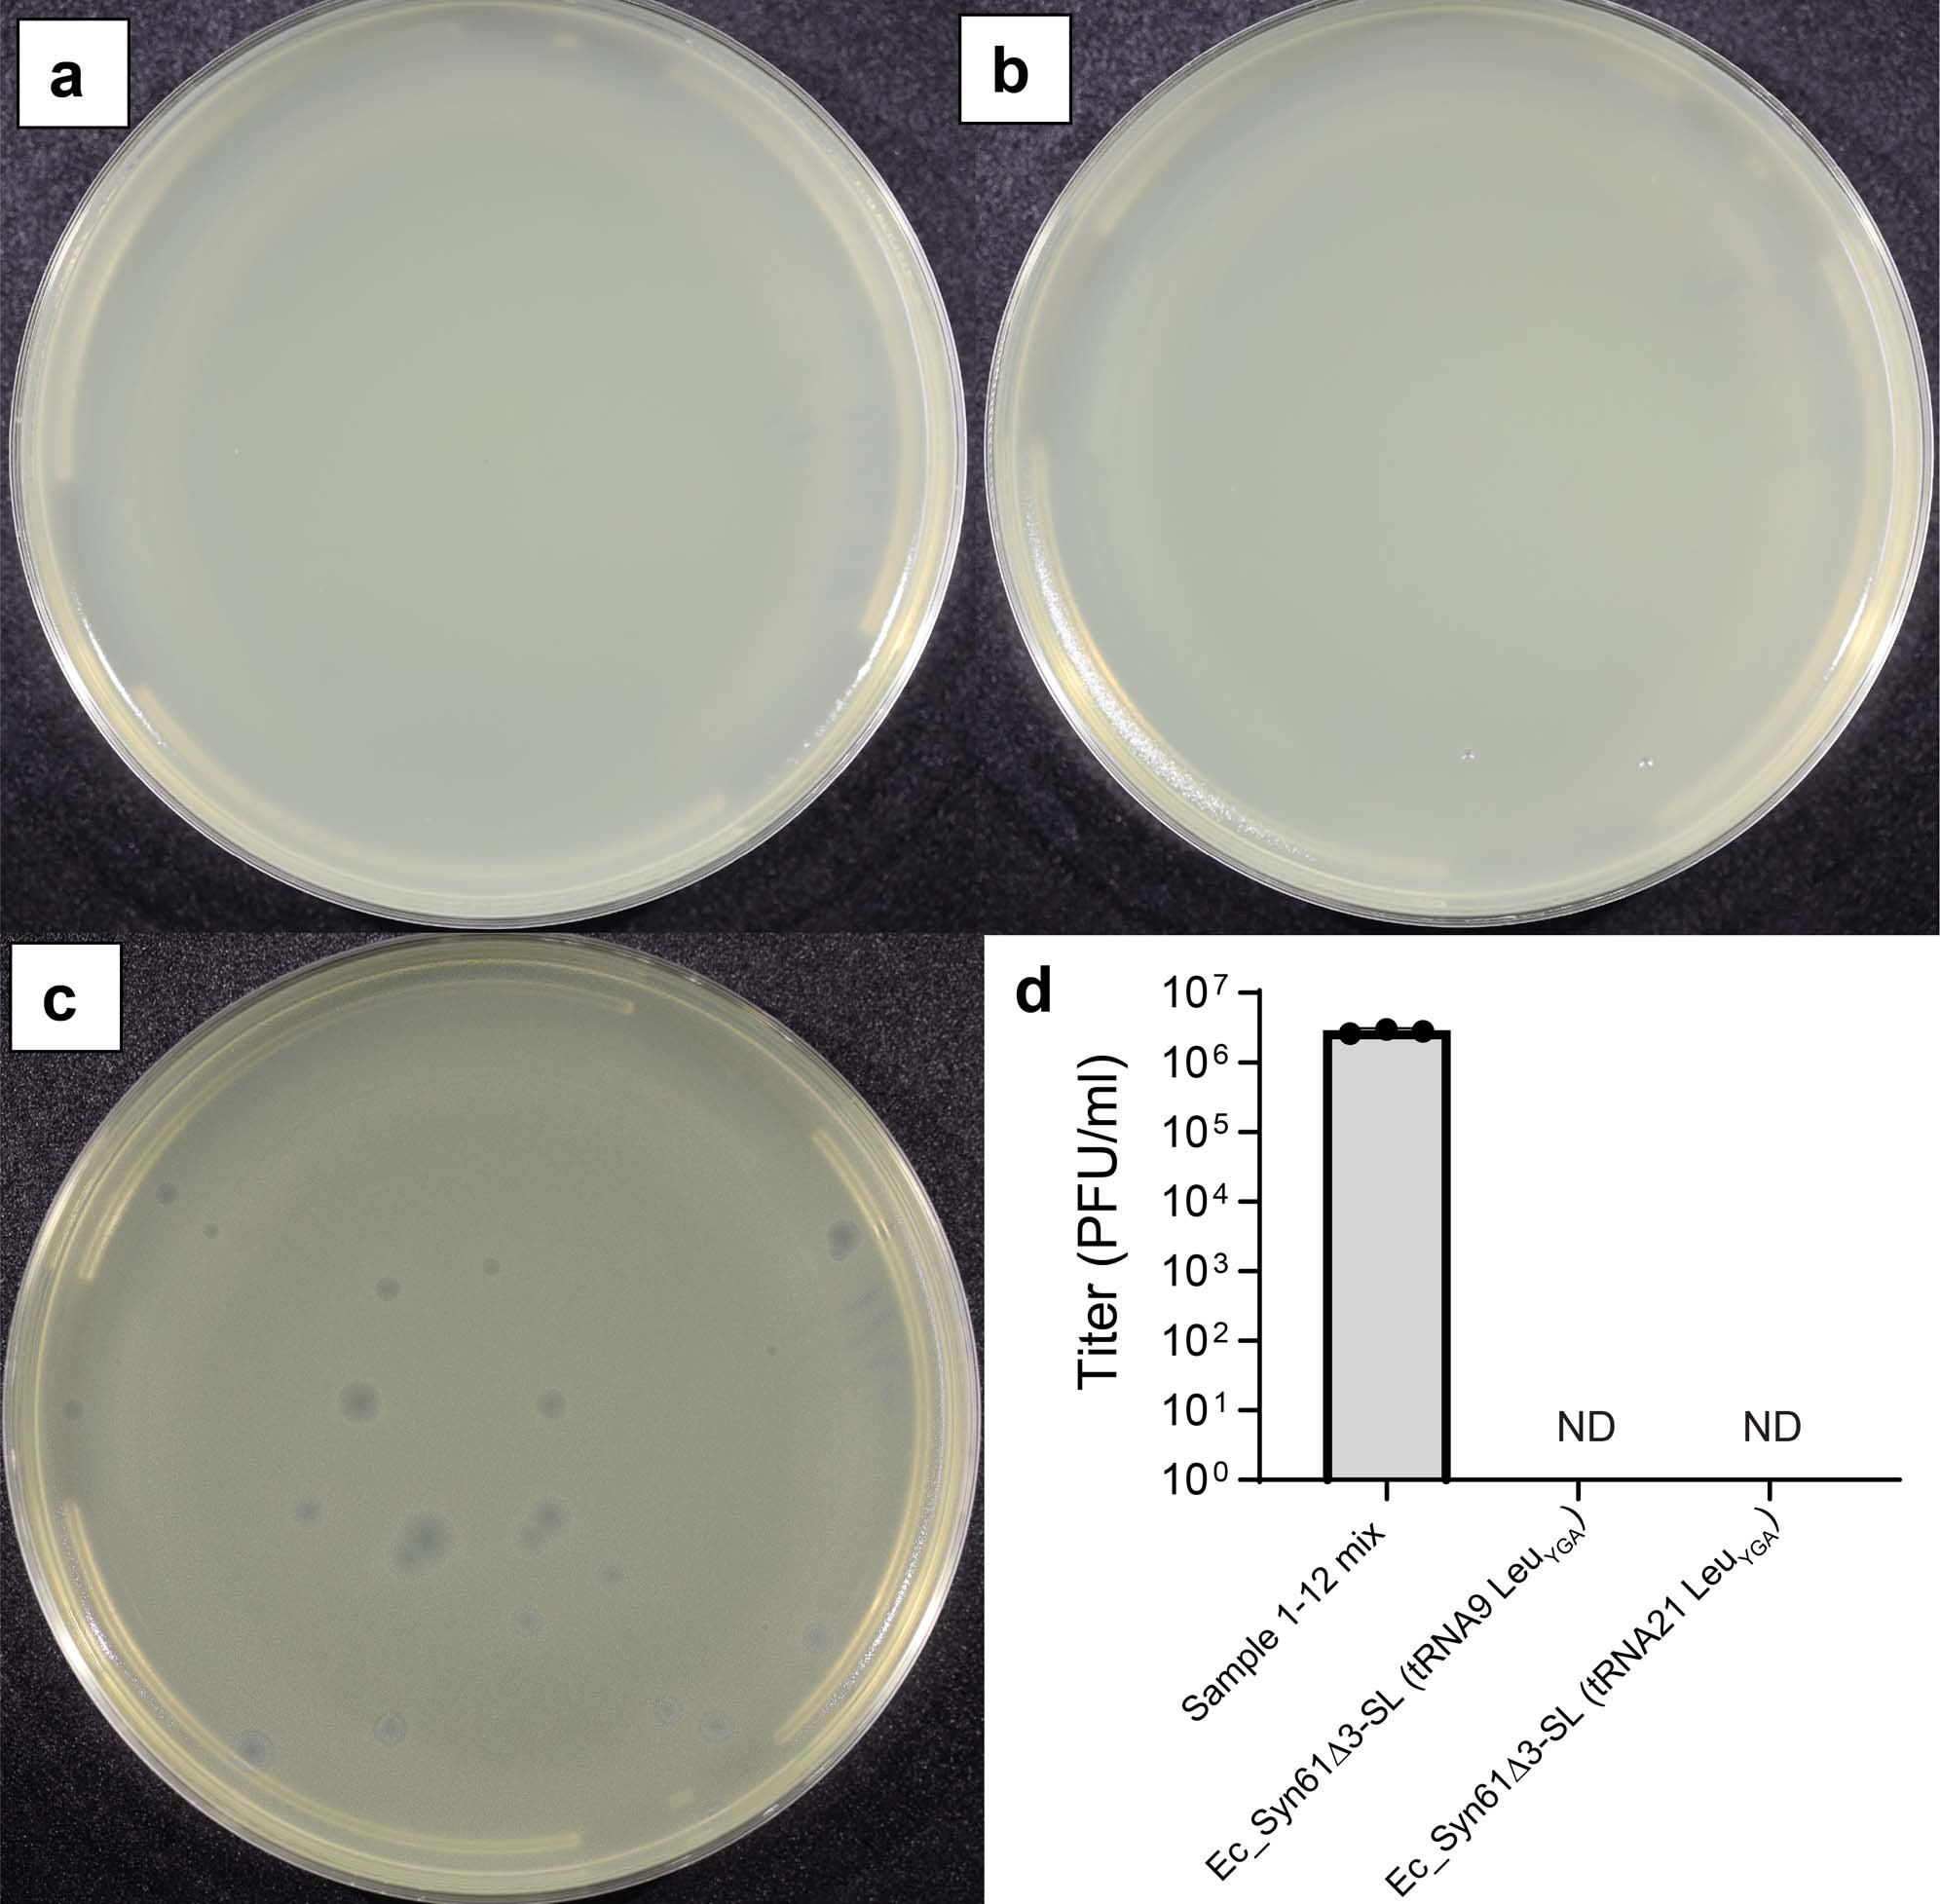
Extended Data Fig. 9

Extended Data Fig. 9: Ec_Syn61∆3-SL resists viruses in environmental samples.
From: A swapped genetic code prevents viral infections and gene transfer
(a) Phage enrichment experiment using Ec_Syn61∆3-SL, expressing KP869110.1 tRNA24 LeuYGA and MF402939.1 tRNA9 LeuYGA, as host. (b) Phage enrichment experiment using Ec_Syn61∆3-SL, expressing KP869110.1 tRNA24 LeuYGA and MF402939.1 tRNA21 LeuYGA, as host. Phage enrichment experiments were performed by mixing early exponential cultures of Ec_Syn61∆3-SL with 10 ml environmental sample mix containing the mixture of Sample 2–13 from our study (Extended Data Table 1a). After two enrichment cycles (Methods, Supplementary Note), filter-sterilized culture supernatants were mixed with phage-susceptible E. coli MDS42 cells in top agar and plated on LBL agar plates to determine viral titer. Enrichment experiments were performed in n = 2 independent replicates with the same result. (c) Lytic E. coli MDS42 phage plaques after 103-fold dilution of the environmental sample mix. d) Lytic phage titer of the environmental sample mix, before and after enrichment on Ec_Syn61∆3-SL. Dots represent the viral titer of the unenriched sample based on three independent experiments, measured on E. coli MDS42 cells. ND represents no plaques detected. Bar represents the mean. Error bar shows standard deviation based on n = 3 independent experiments.
